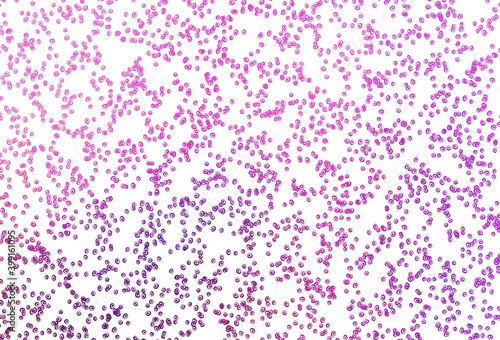

Light Pink, Blue vector template with circles.
Keywords
light,
pink,
blue,
vector,
background,
low,
blur,
geometric,
pattern,
line,
abstract,
gradient,
graphic,
colours,
blurry,
club,
texture,
design,
circle,
dripped,
round,
bubble,
halftone,
dot,
spot,
lap,
disc,
wheel,
cycle,
sphere,
orb,
point,
wall,
fractal,
elegance,
image,
blank,
clean,
connection,
cardboard box,
clear,
shadow